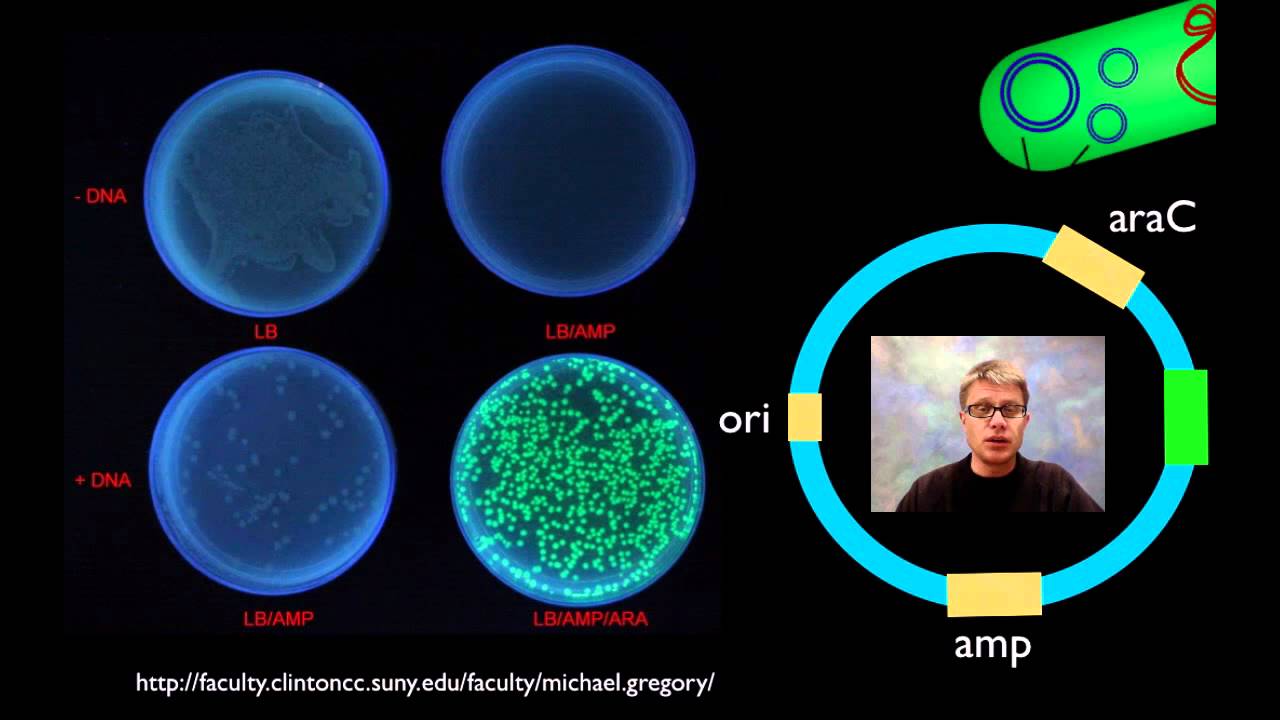
AP Biology Lab 6: Molecular Biology Overview

AP Biology Lab 6: Molecular Biology Overview
Paul Andersen explains the key parts of the molecular biology lab, focusing on transformation and related processes. π¬

Bozeman Science
510.1K views β’ Mar 15, 2012
About this video
Paul Andersen explains the two major portions of the molecular biology lab in AP Biology. He starts by discussing the process of transformation. He explains how you can use the pGLO plasmid to produce glowing E. coli bacteria. He then describes how you can use restriction enzymes and the process of gel electrophoresis to cut and separate DNA.
Intro Music Atribution
Title: I4dsong_loop_main.wav
Artist: CosmicD
Link to sound: http://www.freesound.org/people/CosmicD/sounds/72556/
Creative Commons Atribution License
Intro Music Atribution
Title: I4dsong_loop_main.wav
Artist: CosmicD
Link to sound: http://www.freesound.org/people/CosmicD/sounds/72556/
Creative Commons Atribution License
Tags and Topics
Browse our collection to discover more content in these categories.
Video Information
Views
510.1K
Likes
2.8K
Duration
8:30
Published
Mar 15, 2012
User Reviews
4.2
(102) Related Trending Topics
LIVE TRENDSRelated trending topics. Click any trend to explore more videos.